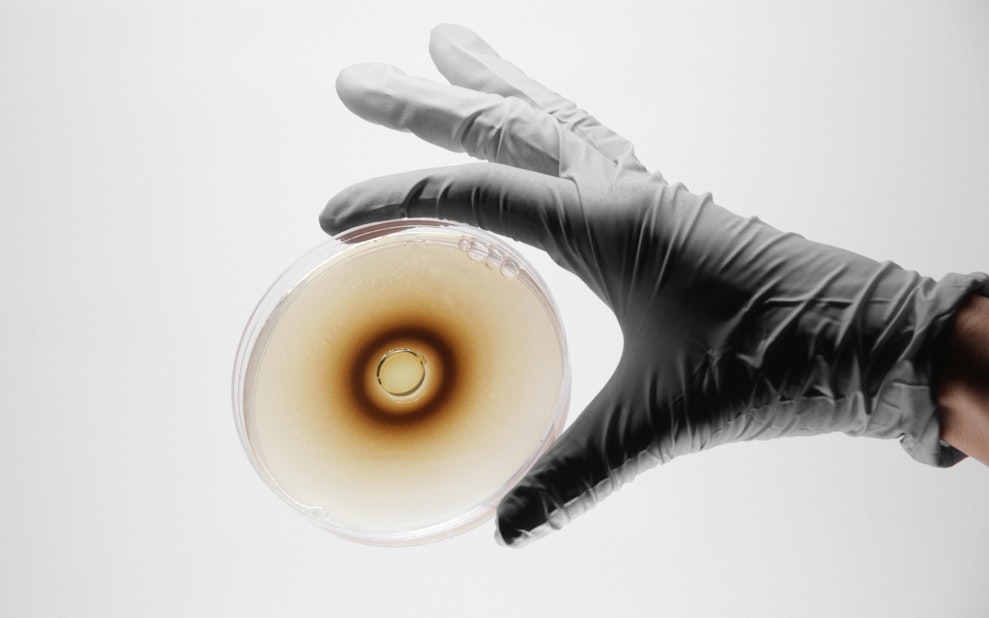
Hybrid Living Materials

Work
Who are we
We are a design company advancing the unification of top-down design engineering with bottom-up biological growth toward the mutual empowerment of Nature and Humanity. We operate at the intersection of computational design, biology, robotics, green chemistry, and ecological engineering. We envision a world where Nature and humans coproduce, cohabitate, and communicate as one.
Our model
Through the creation of products and platforms, we explore three dimensions of collaborating with Nature: coproduction, cohabitation, and communication. They include a new product typology, a novel building typology, and a novel interface typology. We demonstrate these typologies through three projects and the platforms invented to create them: a wearable designed entirely out of a microorganism, a computationally emergent urban environment designed to rewild its site, and a ‘smell computer’ designed to concoct a functionalized fragrance with no harm to the environment. Enter our project pages to learn more.
Past and Present
Building upon previous work and research in the field of Material Ecology, we connect with the past to invent the future. Our academic work has been recognized in publications and exhibitions including two monograph exhibitions at the Museum of Modern Art (MoMA) in NYC, and the San Francisco Museum of Modern Art (SFMOMA).
While the tenor of our academic work focused on “what if” explorations, our current work focuses on “how to” applications. Still, it is possible to trace an aesthetic language running through and across our work: past, present and future. To learn more, please see a list of projects below:






.avif)

.avif)

